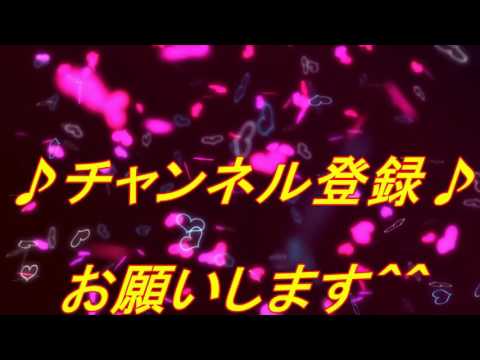

特徴
海を渡り、USAに行ったナガバナナ。
チョコをトッピングされた長い鼻でさらに甘くなった。
チョコバナーナの入手方法
合成進化で入手
ナガバナナとメリケン粉を合成してチョコバナーナに進化

妖怪
ニョロロン
A
レア
ナガバナナ
好物 だがし
イーストカシュー地区の草むらに出現
1つ星コイン(USA)から出現
1つ星コイン(USA)から出現

合成アイテム
メリケン粉
QRコード読み込み

妖怪
ニョロロン
A
新登場
メリケン
チョコバナーナ
ナガバナナとメリケン粉を合成
バスターズT「武王の迷宮」で入手
バスターズT「武王の迷宮」で入手
バスターズTダンジョンで目撃
チョコバナーナの能力
スキル 果汁100%
自分が気絶したとき 味方の ようきゲージを回復する。
攻撃 フルスイング
威力 60
外れやすい
妖術 いかずちの術
威力 雷 50
とりつき おいしいチョコバナナ
とりつかれた妖怪はチョコバナナの甘さでHPが少しずつ回復する。
必殺技 チョコバナビターン!
いりょく 135 x 1
チョコがたっぷりぬられたバナナをスイングして敵1匹をビンタする。
バスターズTでの能力
スキル ジューシー
妖気ゲージが たまりやすくなる。
A こうげき
威力 50
近くの敵に攻撃する
X 気合いの一発
威力 100
気合いの入った攻撃を叩き込む。
Y おにぎりの術
威力 70
自分のHPを回復する。
必殺技 チョコバナビターン!
いりょく 400 x 1
チョコバナーナを魂変化
チョコバナーナの攻略記事

バスターズTのおすすめ妖怪とスキル紹介!
妖怪ウォッチ3の新モード「バスターズT」で活躍するおすすめ妖怪とそのスキルを紹...

すべての妖怪618体を仲間(友達)にする方法まとめ
妖怪ウォッチ3に登場する全妖怪を仲間にする方法をまとめています。全妖怪の一覧は...

バトルで役立つ強力なおすすめ妖怪を紹介!
妖怪ウォッチ3のボスバトルなどで役立つ、強くておすすめの妖怪をご紹介していきま...

妖怪と仲間(ともだち)になる確率をアップする5つのポイント!
バトルに勝利すると敵妖怪がともだちになることがありますが、狙った妖怪がな...
ステータス別!最強妖怪能力ランキング!
妖怪の各ステータスが高い順にランキングを紹介しています。
"ステータス総合...
チョコバナーナが必要となる立て札(妖怪サークル)
チョコバナーナの攻略動画
YouTube DATA APIで自動取得した動画を表示しています

コメント一覧
記事の間違いやご意見・ご要望はこちらへお願いします。
関連カテゴリ・タグ
ニョロロン A 新登場 メリケン